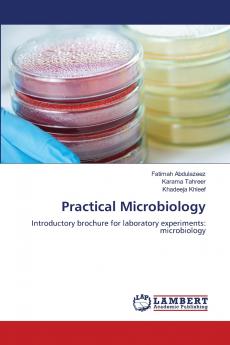
Practical Microbiology

English
Paperback
₹4149
(All inclusive*)
Delivery Options
Please enter pincode to check delivery time.
*COD & Shipping Charges may apply on certain items.
Review final details at checkout.
Looking to place a bulk order? SUBMIT DETAILS
About The Book
Description
Author(s)
The book is a laboratory manual focused on microbiology experiments specifically related to identifying and characterizing Mycobacterium species including M. tuberculosis. It includes various tests such as the Neutral Red test catalase activity susceptibility to pyrazinamide amidase test and nitrate reduction test detailing the biochemical properties of these bacteria. Furthermore it discusses bacterial filtration methods the use of disinfectants like ethanol and isopropanol and radiation for sterilization. Overall it serves as a practical guide for students and researchers in microbiology.
Delivery Options
Please enter pincode to check delivery time.
*COD & Shipping Charges may apply on certain items.
Review final details at checkout.
Details
ISBN 13
9786208426484
Publication Date
-24-02-2025
Pages
-60
Weight
-95 grams
Dimensions
-150x220x3.68 mm